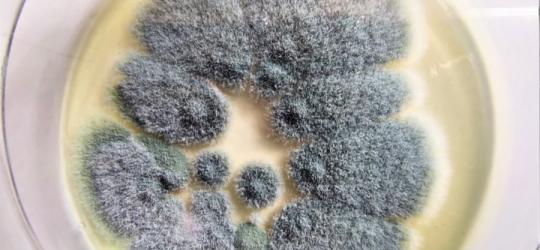
Szalka Petriego z wyhodowanym grzybem Aspergillus, wywołującym aspergilozę.

Sprawdzamy dostępność
leków w 11 076 aptekach
Twoja prywatność jest dla nas ważna
Nasz serwis wykorzystuje mechanizmy między innymi takie jak cookies (ciasteczka), Web Storage i inne, które służą m.in. do zapewnienia optymalnej obsługi podczas wizyty w naszym serwisie. Powyższe mechanizmy mogą być wykorzystywane przez nas jak i przez naszych partnerów. Część z nich jest niezbędna do prawidłowego działania serwisu, w tym zapewnienia niezbędnego poziomu bezpieczeństwa, pozostałe (które możesz kontrolować) są wykorzystywane do:
Kliknij „Akceptuję i przechodzę do serwisu”, aby wyrazić zgodę na przetwarzanie przez nas i naszych partnerów Twoich danych w powyższych celach.
Pamiętaj, że wyrażenie zgody jest dobrowolne, a wyrażoną zgodę możesz w każdej chwili cofnąć, możesz też wycofać zgodę na przetwarzanie Twoich danych tylko w niektórych celach. Jeżeli chcesz dowiedzieć się więcej lub chcesz przeprowadzić konfigurację szczegółową, to możesz tego dokonać za pomocą „Ustawień zaawansowanych”.
Więcej informacji na temat wykorzystywania narzędzi zewnętrznych w naszym serwisie znajdziesz w Regulaminie Serwisu.
Ustawienia zaawansowane
Przetwarzamy informacje pozyskane przy wykorzystaniu technologii cookies, Web Storage i innych wyłącznie w celach wymienionych poniżej. Część z tych informacji jest niezbędna dla działania naszego serwisu, w pozostałym zakresie możesz skonfigurować swoje preferencje w zakresie poszczególnych celów, poprzez zaznaczenie stosownej zgody przy każdym z nich. Możesz też wyrazić zgodę na wszystkie cele poprzez wybranie klawisza „Akceptuję wszystko i przechodzę do serwisu”.
Niezbędne
Zawsze aktywne
Mechanizmy o charakterze niezbędnym są wymagane do prawidłowego działania naszego serwisu. Bez nich część przygotowanych dla Ciebie funkcjonalności nie będzie działać poprawnie lub nie będzie działać wcale. Te mechanizmy są konieczne do funkcjonowania naszego serwisu, dlatego są zawsze aktywne (nie możesz ich wyłączyć).
Funkcjonalne
Mechanizmy funkcjonalne są wykorzystywane przez dodatkowe funkcjonalności serwisu. Możesz z nich zrezygnować, ale w takim przypadku skorzystanie z części funkcjonalności serwisu będzie utrudnione lub wręcz niemożliwe. Informacje zawarte w przedmiotowych mechanizmach mogą być przetwarzane także przez naszych partnerów (Facebook, Disquas, Youtube, Whitepress). Więcej informacji o wykorzystywanych przez nas narzędziach zewnętrznych znajdziesz w naszej Polityce Prywatności wskazanej w Regulaminie naszego Serwisu.
Analityczne i statystyczne
Mechanizmy analityczne pomagają nam zrozumieć w jaki sposób użytkownicy poruszają się po naszym serwisie, a także które strony serwisu cieszą się największą popularnością. Dzięki tym mechanizmom jesteśmy w stanie lepiej przygotowywać nowe funkcjonalności naszego serwisu oraz optymalizować działanie już istniejących. Informacje zawarte w przedmiotowych mechanizmach mogą być przetwarzane także przez naszych partnerów (Google LLC, Microsoft Corporation). Więcej informacji o wykorzystywanych przez nas narzędziach zewnętrznych znajdziesz w naszej Polityce Prywatności wskazanej w Regulaminie naszego Serwisu.
Reklamowe
Mechanizmy reklamowe są wykorzystywane przez nas oraz naszych partnerów do budowania kontentu reklamowego w naszym serwisie – lista partnerów może ulegać zmianie, jej aktualną wersję zawsze znajdziesz w tym miejscu. Więcej informacji o wykorzystywanych przez nas narzędziach zewnętrznych znajdziesz w naszej Polityce Prywatności wskazanej w Regulaminie naszego Serwisu.
Nasi partnerzy:
Reklamowe niespersonalizowane
Mechanizmy wykorzystywane są do wyświetlenia reklamy na podstawie wyłącznie aktualnych informacji kontekstowych – np. zawartości otwartej strony, aktualnie wyszukiwanego hasła, przybliżonej lokalizacji (np. na poziomie miasta).
Reklamowe spersonalizowane
Reklamy spersonalizowane to reklamy dopasowane do potrzeb użytkowników. Mechanizmy wykorzystywane są do wyświetlenia reklamy na podstawie danych dotyczących wcześniejszych zachowań użytkownika, np. wyszukiwanych haseł, lokalizacji lub wizyt na stronach internetowych lub w aplikacjach. Zaznaczenie tej opcji pozwoli nam i naszym partnerom na dostarczenie treści lepiej dostosowanej do Twojej osoby. Jeśli zablokujesz te mechanizmy, reklamy skierowane do Ciebie będą gorzej dopasowane.
Sprawdzamy dostępność
leków w 11 076 aptekach